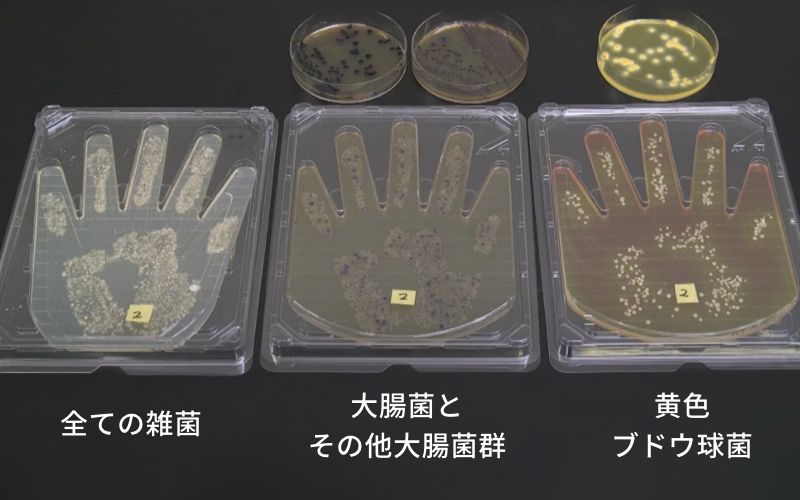

家庭で実践! 食中毒予防策 手洗い・買い物・保存編
監 修 | 金井美恵子 東都大学管理栄養学部教授
新型コロナウイルス感染症の流行により、
以前よりも手洗いを習慣にされている方も多いでしょう。
しかし、食中毒予防の観点では、
より適切な手順による手洗いが重要です。
手洗いの効果をより発揮させるため、
次に紹介する正しい手洗いの手順を参考にしてください。
正しい手洗いの手順
-
石鹸がよく泡立つように手を濡らします。
-
石鹸やハンドソープを手に取り、よく泡立てます。
-
まずは大きな面積の手のひらと甲を左右交互にこすり洗いします。
-
左右の指を交差させるなどして、各指と指の間も洗います。
-
指先や爪の間も洗います。
-
親指は反対の手を使い、包みながらねじるように洗います。
-
忘れがちな手首も反対の手を使い、ねじるように洗います。
-
蛇口の取っ手を石鹸で洗い流してから、石鹸と汚れを十分に洗い流します。
-
清潔で乾いたタオルやペーパータオルなどで水気を拭き取ります。
-
手洗い完了!
水洗いだけでも効果はありますが、石鹸やハンドソープなどを用いて手洗いした方がより効果的です。調理前であれば、アルコール消毒もおすすめします。

時間に決まりはありませんが、手のひらと甲、指と指の間、指先、そして手首と、すみずみまでていねいに洗うよう心がけてください。また、2度洗いするとより効果があります。

指輪をしたままでは、その部分の汚れを落としきれない可能性があるため、指輪や時計などのアクセサリー類は外しましょう。

生肉などに触れた手には食中毒の原因となる細菌等が付着する可能性があるため、食材に触れたら、ほかの食材や調理器具に触れる前に手洗いを実践しましょう。
生の鶏肉を触った手の細菌を培養すると、大腸菌や黄色ブドウ球菌など、多くの菌に汚染されていることがわかります。
画像提供:金井美恵子 東都大学管理栄養学部教授
肉や魚介類は買い物の最後に!
スーパーなどで食材を購入する際は、冬期であれ店内は暖房が効いており、室内温度は細菌などの微生物が増殖しやすい温度まで上昇している可能性があります。肉や魚介類は最後にカゴに入れ、できるだけ素早く会計を済まして帰宅しましょう。帰宅までに時間がかかる場合は、保冷バッグを使用したり、店舗で提供されている氷などで食材を冷やし、帰宅中に食材の温度が上がらないようにしましょう。
ポリ袋に入れ
ドリップ漏れを防止!
食材購入の順番と同様に注意したいのが、ドリップ漏れによる他の食材の汚染です。パック詰めされた肉や魚からは「ドリップ」と呼ばれる汁が流れ出ていることがあります。もしも、その食材に細菌等が付着していた場合、ドリップを通じて細菌等が増殖します。また、保存容器の隙間から細菌等を含んだドリップが染み出せば、他の食材への汚染も考えられます。これを防ぐため、買い物袋へ入れる際は必要に応じてポリ袋に入れ、ドリップの流出を防ぐことが重要です。肉の切り身等を保存する際は、冷蔵庫内で他の食材と保存場所を分ける、余分な水分を拭き取るなど、ドリップによる二次汚染を未然に防ぐことが大切です。

表示された保存方法を厳守!
購入した食材を保存する際は、食品表示の保存方法に従い、冷蔵庫等で正しく保存することが大切です。例えば、「要冷凍」と表示された食材を冷蔵で保存してしまった場合、安全とは言えません。また、消費期限と賞味期限の違いを理解しておくことも重要です。消費期限は正しい保存方法に従い保存されることを前提とし、その食材を安全に食べられる期限であり、期限を越えた場合は食べてはいけません。一方、賞味期限は品質や味わいが保たれる期限であり、期限を過ぎてもすぐに食べられなくなるわけではありません。いずれの期限も未開封のまま保存していた場合の日付や期間であることをお忘れなく。
大きな食材は
小分けして保存を!
肉や魚介類から流れ出たドリップを他の食材に触れないようにすることはもちろん、例えばかたまり肉や大きな一尾の魚などは、そのまま冷凍保存してしまっては、食材が保存に適した温度になるまで時間がかかります。そこで提案したいのは、あらかじめ1回の食事で消費する分量へ小分け(魚の場合は半身や切り身状態に)して保存することです。小分けにすれば早く冷凍でき、また、使用する量だけ解凍すればよいので、再凍結を防ぎ、品質を保つことができます。なお、小分け保存する際に気をつけたいのは消費し忘れてしまうこと。袋やパッケージには小分け保存した日付や表示された期限を記入し、食材が傷んでしまう前に調理して美味しくいただきましょう!

今週のまとめ
手洗いは石鹸などを使用し、
正しい手順でおこないましょう!
肉や魚介類は最後に購入し、
移動中も保冷を!
食品表示に従った方法で、
食材を正しく保存しましょう!
お問合せ先
大臣官房広報評価課広報室
代表:03-3502-8111(内線3074)
ダイヤルイン:03-3502-8449




